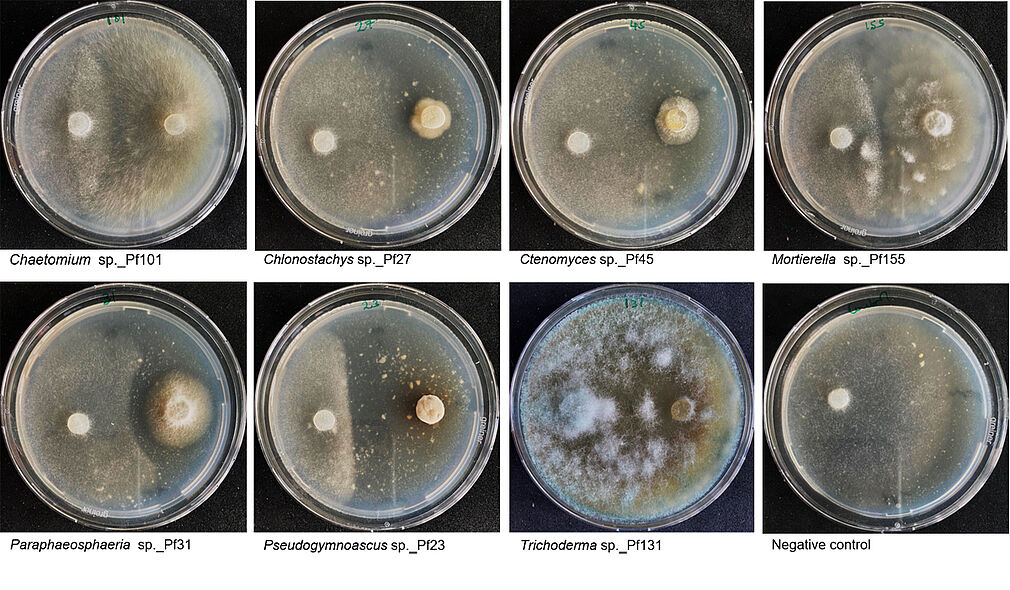
In-vitro-Hemmwirkung von Pilzisolaten gegen P. infestans (©Philemon Orwa).

In dieser Arbeit haben wir Chaetomium subaffine, Clonostachys sp. und Pseudogymnoascus sp., die aus Tomatengewebe gewonnen wurden, als potenzielle Kandidaten für die biologische Bekämpfung des Kraut- und Knollenfäule-Erregers Phytophthora infestans identifiziert. Dabei wurde ein integrierter Ansatz verfolgt, der die kultivierungsabhängige Charakterisierung mit Mikrobiomanalysen verbindet und die Ergebnisse im Zusammenhang mit der Gesundheit von Tomatenpflanzen bewertet. Unser strategischer Ansatz erhöhte die Wahrscheinlichkeit, Pilzkandidaten mit starkem biologischem Bekämpfungspotenzial und kommerzieller Rentabilität sowohl durch In-vitro- als auch durch Ad-planta-Tests zu identifizieren. Diese Ergebnisse verbessern unser Wissen über den Zusammenhang zwischen biologischen Fungiziden und dem Pflanzenmikrobiom und liefern wertvolle ökologische Daten für die Identifizierung wirksamer Antagonisten, die für eine nachhaltige Bekämpfung von P. infestans geeignet sind.
Link zur Veröffentlichung: https://doi.org/10.1371/journal.pone.0335007